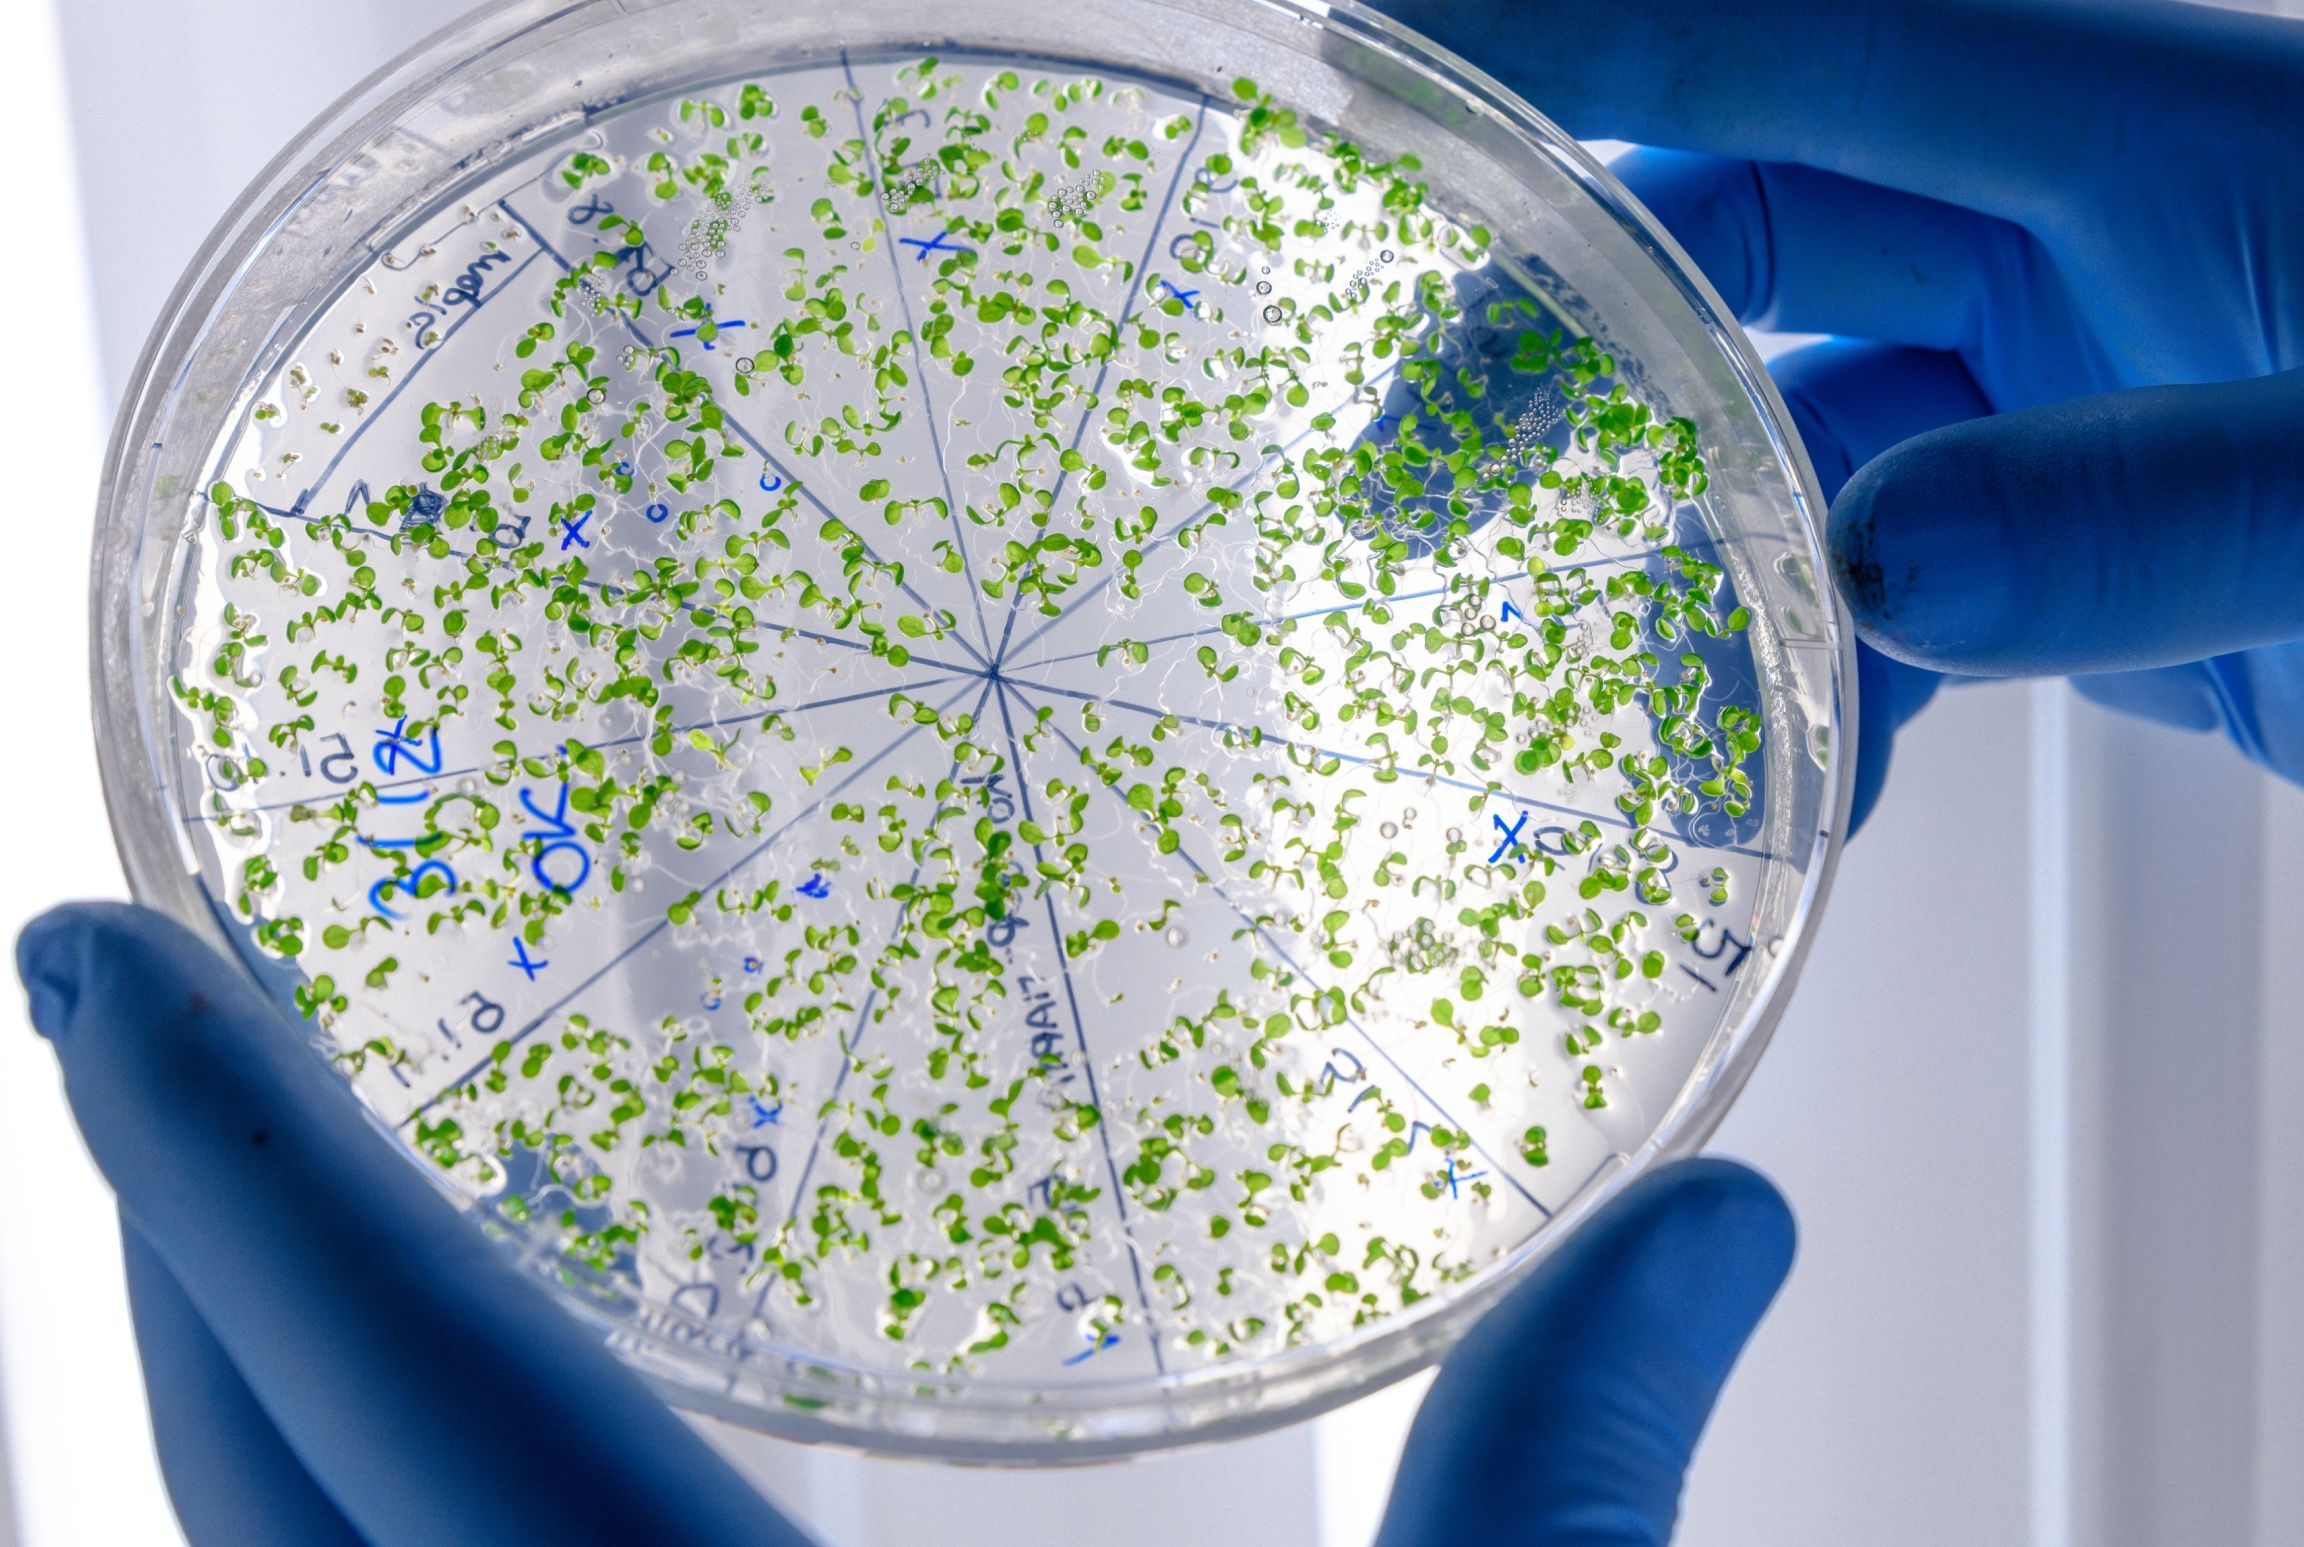

Najnoviji članci

Moždani udar
05. jun 2024.
Stafilokoke: vrste, infekcije i liječenje
05. jun 2024.

Microsporum Canis – najčešći uzročnik dermatomikoza u Crnoj Gori
05. jun 2024.

Šta su karotidne arterije?
05. jun 2024.

Kako smanjiti rizik od kardiovaskularnih bolesti?
05. jun 2024.

Specijalistički pregledi i liječenje u endokrinološkoj ambulanti
28. feb 2022.

Oralna rehidracija - ključ tretmana akutne dijareje
07. feb 2022.

Poremećaji u ishrani u prvoj godini života i ranom djetinjstvu
07. dec 2021.

Kašalj kod djece – uzroci i kako pravilno reagovati
30. nov 2021.

Dijabetes u Crnoj Gori: stanje, izazovi i faktori rizika
13. nov 2021.

Da li ste kandidat za nove kardiološke ljekove?
03. nov 2021.

Koja je vaša formula za zdravo srce?
14. okt 2021.